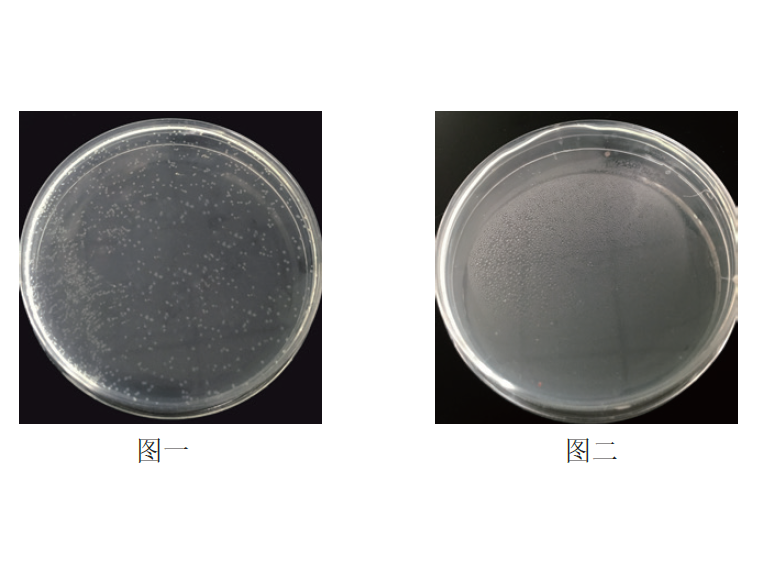
NovoRec® plus One step PCR Clo

相关产品推荐更多 >
万千商家帮你免费找货
0 人在求购买到急需产品
- 详细信息
- 询价记录
- 文献和实验
- 技术资料
- 库存:
大量
- 保存条件:
-20℃
- 规格:
20次/100次
| 规格: | 20次 | 产品价格: | ¥600.0 |
|---|---|---|---|
| 规格: | 100次 | 产品价格: | ¥2000.0 |


| 产品组成 | A包装规格(20次) | B包装规格(100次) |
|---|---|---|
| NovoRec® Plus Recombinase | 20μl/管 | 100μl/管 |
| 5×Reaction Buffer | 200μl/管 | 1ml/管 |
| NovoRec® pUC19 (Linearized, 50ng/μl) | 20μl /管 | 20μl/管 |
| 800bp PCR Fragments (Positive Control, 50ng/μl) | 20μl /管 | 20μl/管 |
| Novoprotein 2×SpecificTM Taq Master Mix | 1ml | 1ml×5 |

风险提示:丁香通仅作为第三方平台,为商家信息发布提供平台空间。用户咨询产品时请注意保护个人信息及财产安全,合理判断,谨慎选购商品,商家和用户对交易行为负责。对于医疗器械类产品,请先查证核实企业经营资质和医疗器械产品注册证情况。
- 作者
- 内容
- 询问日期
文献和实验or Directional TOPO® Cloning, optimal results are achieved most often when using a 1:10 dilution of the PCR product.Fresh PCR ProductThe use of fresh PCR products in TA, TOPO® TA, and Directional TOPO® Cloning is recommended due the potential presence
of tissue/ cell harvest. Dynabeads® mRNA DIRECT™ Kit protocols can be scaled up or down to suit specific sample source and quantity. Please see section "Sample Guidelines and Scaling" before preparing the sample, and for recommended bead and buffer volumes
SuperScript III One-Step RT-PCR System with Platinum® Taq High Fidelity
for 25 or 100 amplification reactions of 50 µl each. Note: This kit has been optimized for end-point RT-PCR. For quantitative real-time RT-PCR, use the SuperScript™ III Platinum® One-Step Quantitative RT-PCR System. 实验











